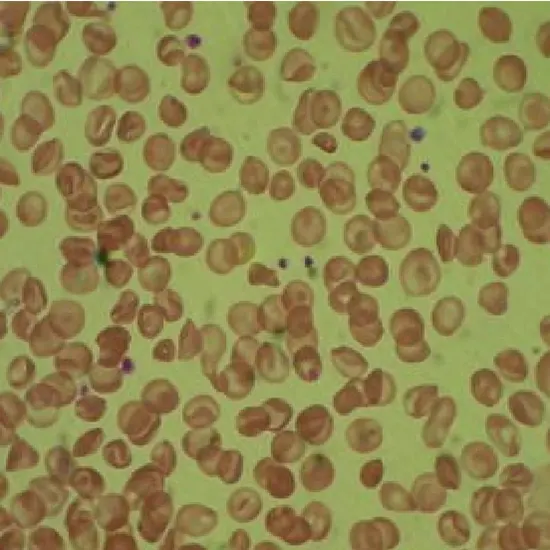

Book Hemoglobin (Hb) D-Iran Appointment Online Near me at the best price in Delhi/NCR from Ganesh Diagnostic. NABL & NABH Accredited Diagnostic centre and Pathology lab in Delhi offering a wide range of Radiology & Pathology tests. Get Free Ambulance & Free Home Sample collection. 24X7 Hour Open. Call Now at 011-47-444-444 to Book your Hemoglobin (Hb) D-Iran at 50% Discount.
When a patient first presents for a diagnosis or course of treatment for -thalassemia, it is frequently discovered that Hb D-Iran also exists. When Hb D-Iran is homozygous, as in the instance described by Thornburg CD et al., anemia, poikilocytosis, and moderate hemolysis may be present.
| Test Type | Hemoglobin (Hb) D-Iran |
| Includes | Hemoglobin (Hb) D-Iran (Pathology Test) |
| Preparation | |
| Reporting | Within 24 hours* |
| Test Price |
₹ 200
|

Early check ups are always better than delayed ones. Safety, precaution & care is depicted from the several health checkups. Here, we present simple & comprehensive health packages for any kind of testing to ensure the early prescribed treatment to safeguard your health.